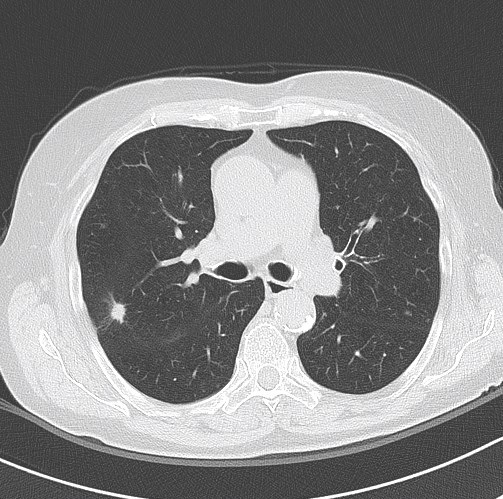

Patient Case Reports by Dr. med. MSc. PhD Aleš Rozman
University Clinic of Pulmonary and Allergic Diseases, Golnik, Slovenia
Introduction
Lung cancer is the most common cancer among men and women worldwide. Due to screening programs and improved access to CT-scans for various other indications more and more lung lesions in the early stages of its development are discovered. Diagnostics of small peripheral lesions are one of the major challenges in the interventional pulmonology. The majority of them are benign and histological diagnosis is necessary to avoid futile lung resections. Here, we report the diagnostic procedures in two patients with small lesion at the periphery of the right upper lobe.
Case Presentation 1 – Patient History and Assessment
A 64-year old male was referred due to an asymptomatic lesion in the right upper lobe. He reported symptoms of respiratory infection several weeks ago with cough, purulent sputum and mild fever up to 38°C. Chest X-ray (CXR) was performed since he was an ex-smoker with 70 pack-years of smoking history. The lesion persisted three weeks later on the follow-up CXR. The patient denied chronic illnesses. He regularly took aspirin 100 mg/d. After the short course of treatment with amoxicillin-clavulanic acid his symptoms had gradually disappeared, and he had no further complaints. Clinical examination including detailed examination of respiratory system was in normal range. Blood biochemistry, coagulation tests and differential blood count were in the normal range, except CRP was slightly elevated to 12,6 mg/l.
Lung function tests: vital capacity 4930 ml (110%), FEV1 2720 ml (79%), TI 55%, diffusion capacity 81%. There was no response in FEV1 to bronchodilator challenge test. On the CT scan a solitary 12 mm spiculate lesion was discovered in the 3rd segment of the right upper lobe near the interlobar fissure, suspicious for primary long tumor. No metastases or enlarged lymph nodes were observed. Additionally, moderate centrilobular emphysema was described.
Examination
Patient was referred to flexible bronchoscopy in deep sedation. Careful preprocedural planning didn’t reveal any clear bronchus sign, although several small bronchi were visible in the vicinity. The procedure was initially performed with a standard flexible bronchoscope (Olympus BF-1TH190), but the operator reached only the subsegmental level of bronchi and was unable to introduce the radial EBUS probe in the vicinity of the lesion. The procedure was continued with ultrathin flexible bronchoscope (Olympus BF-MP190F), where 3 more levels of bronchial branching were reached, which enabled the operator to insert the radial EBUS probe in the desired direction. The lesion was visible on one side of the radial EBUS probe and the interlobar fissure was recognizable. The position was secured by fluoroscopic view and a forceps was introduced thereafter to obtain 5 biopsy specimens. Rapid on-site evaluation (ROSE) was performed, but the pathologist didn’t confirm malignant cells in the specimens. The procedure was continued with the PeriView FLEX needle. Malignant cells were obtained from the lesion and final cytological diagnosis was adenocarcinoma of the lung.
Patient was presented on the multidisciplinary meeting as T1bN0M0 adenocarcinoma of the lung, where a VATS lobectomy was advocated as the preferred modality of treatment.
Case Presentation 2 – Patient History and Assessment
An 84-year old female was referred for diagnostic of asymptomatic lesion in the right upper lobe, accidentally found on CXR. Patient reported 5 pack-years of smoking history but quitted smoking 30 years ago. She visited the doctor two months ago with the signs of respiratory infection with cough, mucous expectoration and runny nose. She took antibiotic treatment for a few days while symptoms retreated. The lesion in the right upper lobe, found on the first CXR still persisted 3 weeks later and the patient was referred to chest CT-scan. Patient was treated for arterial hypertension, osteoporosis, hypothyroidism and chronic gastro-esophageal reflux, but was in good general physical strength and fitness. Clinical examination including detailed respiratory examination was normal. Blood biochemistry, coagulation tests and differential blood count were in the normal range, except elevated blood creatinine 149 micg/l.
Lung function tests: vital capacity 2410 ml (111%), FEV1 1760 ml (107%), TI 73%, diffusion capacity 85%. On the CT scan an 11 mm spiculate lesion was discovered in the 2nd segment of the right upper lobe near the interlobar fissure, suspicious for primary long tumor.
Examination
Patient was referred to flexible bronchoscopy in deep sedation. Careful preprocedural planning didn’t reveal any clear bronchus sign, with several small bronchi near the lesion. Bronchoscopy was performed with standard flexible bronchoscope (Olympus BF-1TH190), but the operator was unable to introduce the radial EBUS probe in the vicinity of the lesion due to the lesion´s location. Switching to the ultrathin flexible bronchoscope (Olympus BF-MP190F) the operator was able to reach the 7th generation of bronchial branching. The radial EBUS probe could be advanced into the branching towards the lesion and the lesion could be detected by radial EBUS probe. The lesion was visible on one side of the radial EBUS probe and the interlobar fissure was recognizable. The position was secured by fluoroscopic view and the biopsy forceps used to obtain biopsies. Rapid onsite evaluation (ROSE) was performed, and the pathologist confirmed malignant cells in the specimens. The final histological diagnosis was adenocarcinoma of the lung.
Patient was presented on the multidisciplinary meeting as T1bN0M0 adenocarcinoma of the lung, where a stereotactic external body irradiation was advocated as the preferred modality of treatment.
Summary
We presented two cases of small peripheral lung lesions with difficult access due to lack of clearly visible bronchial sign. In our experience, the standard BF-1TH190 bronchoscope could be advanced to the level of subsegmental bronchi, but the lesions were not in the same axis as the distal tip of the bronchoscope at that point and could not be reached either by radial EBUS probe or by biopsy accessories. The ultrathin bronchoscope BF-MP190F enabled us to navigate 3 – 4 generations of bronchi deeper. With this advantage the access to target lesions was possible and subsequent biopsies were successful.
The use of the radial EBUS probe to localize the lesion was complemented by fluoroscopy which confirmed the position so to secure the subsequent biopsies from the same spot. Bronchoscopy in presented cases would have been non-diagnostic if standard procedure had not been switched to the ultrathin bronchoscope BF-MP190F. The crucial element in these procedures was better access to the lung periphery which enabled lesion detection with radial EBUS probe and subsequent biopsies. A thinner bronchoscope with combined navigation methods like fluoroscopy in these cases seems to improve the chance to get tissue diagnosis from small peripheral lung lesions.
- Keyword
- Content Type